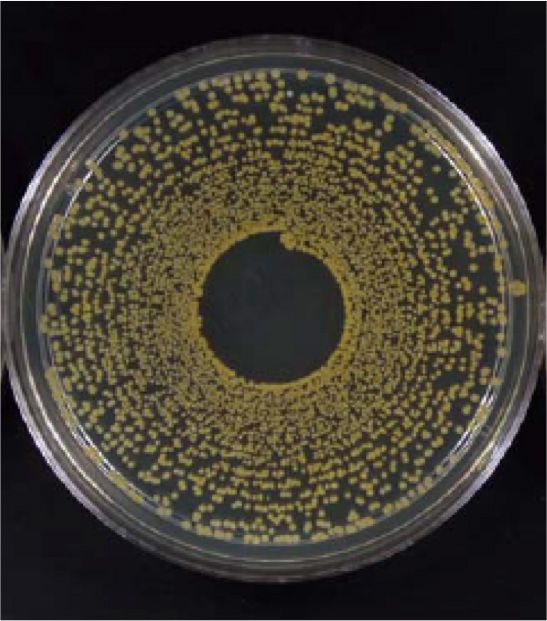
ポリジン加工なし
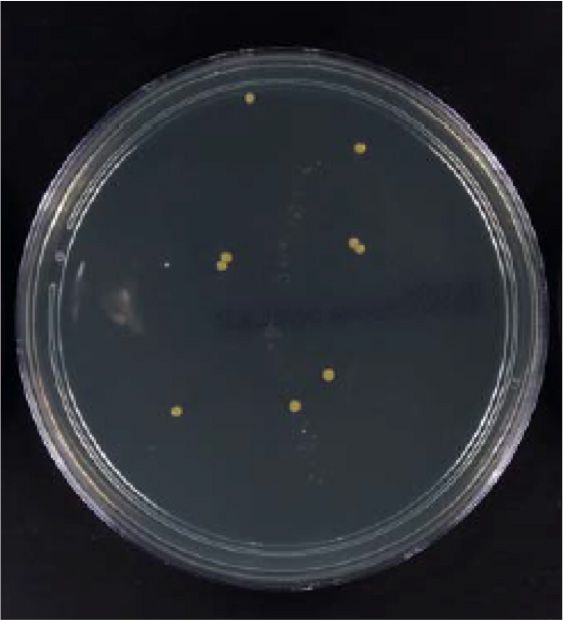
ポリジン加工(15回洗濯)

- ユニフォーム通販TOP >
- ポリジン加工とは
ポリジン加工とは

■ニオイの原因
汗や皮脂、汚れが繊維の奥にたまり それをエサに菌が繁殖

菌が汚れを分解するとイヤ~なニオイが発生します。
さらに、洗濯までの時間が長いと菌が増え続けニオイが強くなりやすいんです。
※一度染みついたニオイは洗濯しても落ちにくい「残り臭」になります。
■ニオイを消す方法
すぐに洗濯する

消臭スプレーなど

熱湯や漂白等で菌・ニオイをなくす



ポリジン加工で解決!
~面倒な特別ケアもいらず、いつでも快適&清潔~
■ポリジンってなに?
スウェーデン生まれの

ニオイの発生源から防ぎます。

ポリジンはニオイの原因となる菌の成長を抑制しニオイの発生を防ぎます。
その効果は洗濯も衰えなく長時間維持されます。
リサイクルされた銀を可能な限り使用しており、
環境にもやさしく、無香料なので安心安全です。
73℃以上のお湯で洗濯しないとニオイ菌は除去されず数年でさらに増殖・・
ポリジン加工済みならニオイの原因菌が繁殖しません!
ポリジン加工なし
ポリジン加工
(洗濯後)
ポリジン加工
(15回洗濯)
ポリジンの4つの特徴
抗菌防臭
銀イオンが繊維上のバクテリアの成長を抑制し、ニオイを元から防ぎます。
効果の持続
素材に施された加工で、洗濯しても長期間効果が続きます。
環境配慮
リサイクルされた銀を使用し、環境負荷を抑えた設計です。
無香料
無香料で周りの人にも安心・安全に使えます。

世界で認められているから安心安全

安心安全のbluesign®を取得
繊維業界において、環境、労働、消費者の観点における持続可能なサプライチェーンを経た製品に付与される認証のことで世界で最も厳しい基準と言われています。スイスに拠点を置くブルーサインテクノロジーによって管理されており、抗菌防臭加工「ポリジン」はこの認証を受けたことにより、労働環境や環境への安全性、持続性が証明されています。

Sweden/スウェーデン
エチケットもエコロジーも大切にしたいという、北欧流のサスティナブルな考え方が込められたスウェーデン生まれ。
世界約500ブランドで採用
スポーツブランドや、寝具メーカーをはじめとする約500ブランドで採用。安心・安全の技術「ポリジン」でニオイ対策をはじめませんか?


ポリジン加工とは商品一覧
ポリジン加工とはを販売するユニフォームの通販。常時20万点以上の豊富な品揃え。プリント・刺繍加工も対応中!
- 人気ランキング 第1位

Lifemax MS3121 ライン入りベーシックドライポロシャツ(ポリジン加工)(男女兼用)
商品番号: 36-MS3121 定価: 3,410円 (税込) 売価: 1,938円(税込)  (10)
(10)抗菌防臭加工を施した爽快着心地のドライポロシャツ
- 人気ランキング 第2位

Lifemax MS3122 裾ラインリブドライポロシャツ(ポリジン加工)(男女兼用)
商品番号: 36-MS3122 定価: 4,180円 (税込) 売価: 2,298円(税込)  (6)
(6)抗菌防臭加工をプラス。汗をかいても乾きやすい介護にオススメのドライポロシャツ
- 人気ランキング 第3位

Lifemax MS1154 4.3オンスドライTシャツ(ポリジン加工)(男女兼用)
商品番号: 36-MS1154 定価: 1,540円 (税込) 売価: 924円(税込)  (3)
(3)高機能素材とこだわりのシルエット、そしてポリジン・ステイフレッシュが生み出す快適なドライTシャツ。
- 4位

Lifemax MS3119 4.3オンス ボタンダウンドライポロシャツ(ポリジン加工)(男女兼用)
商品番号: 36-MS3119 定価: 2,860円 (税込) 売価: 1,716円(税込)  (5)
(5)抗菌防臭加工を施した機能性素材で、清涼感のあるボタンダウンポロシャツ。
- 5位

Lifemax MS1165 ノースリーブTシャツ ドライ(ポリジン加工)
商品番号: 36-MS1165 定価: 1,760円 (税込) 売価: 1,056円(税込) - 6位

Lifemax MS3120 ベーシックドライポロシャツ(ポリジン加工)(男女兼用)
商品番号: 36-MS3120 定価: 2,970円 (税込) 売価: 1,782円(税込)  (2)
(2)
- 7位
![Bonmax RB4172 [通年]ポリジン 長袖ブラウス [抗菌防臭/ニット/吸水速乾/透け防止]](https://img0.land-mark.biz/goods.img/8/41218/main.jpg)
Bonmax RB4172 [通年]ポリジン 長袖ブラウス [抗菌防臭/ニット/吸水速乾/透け防止]
商品番号: 36-RB4172 定価: 9,130円 (税込) 売価: 5,935円(税込) 抗菌防臭加工「ポリジン」を付与したニット素材の半袖ブラウス。ニット素材だから伸縮性抜群。
- 8位
![Bonmax AV1289 [通年]ポリジン ベスト[抗菌防臭/ストレッチ/ストライプ]](https://img0.land-mark.biz/goods.img/5/43115/main.jpg)
Bonmax AV1289 [通年]ポリジン ベスト[抗菌防臭/ストレッチ/ストライプ]
商品番号: 36-AV1289 定価: 16,500円 (税込) 売価: 10,725円(税込) 立体的なパターン設計と縦長効果のある細いピッチのカラーストライプでおしゃれと着ヤセが叶うベスト
- 9位
![Bonmax AD8201 [通年]ポリジン プルオーバー[抗菌防臭/ツイード調/ニット]](https://img0.land-mark.biz/goods.img/1/43131/main.jpg)
Bonmax AD8201 [通年]ポリジン プルオーバー[抗菌防臭/ツイード調/ニット]
商品番号: 36-AD8201 定価: 20,350円 (税込) 売価: 13,228円(税込) 深みのあるツイード調ニット素材でやさしい着心地のプルオーバー。体型もカバーするウエストフレアーとリボンカラーデザインで、おもてなしシーンに着映えます。
- 10位
![Bonmax BCD8704 [春夏用]ポリジン プルオーバー シャドーチェック [吸汗速乾/ストレッチ/シャドーチェック/後ファスナー開き]](https://img0.land-mark.biz/goods.img/5/42755/main.jpg)
Bonmax BCD8704 [春夏用]ポリジン プルオーバー シャドーチェック [吸汗速乾/ストレッチ/シャドーチェック/後ファスナー開き]
商品番号: 36-BCD8704 定価: 22,000円 (税込) 売価: 14,300円(税込) 上品なシャドーチェックに、トレンド感のあるおしゃれ見えする五分袖のプルオーバー。2WAYストレッチで動きやすく、抗菌防臭加工で汗ばむ季節も安心。再生PET「RENU®」を使用したエコ素材で環境にも配慮。
- 11位
![Bonmax AS2328 [通年]ポリジン Aラインスカート[無地/ストレッチ/抗菌防臭]](https://img0.land-mark.biz/goods.img/6/41206/main.jpg)
Bonmax AS2328 [通年]ポリジン Aラインスカート[無地/ストレッチ/抗菌防臭]
商品番号: 36-AS2328 定価: 14,300円 (税込) 売価: 9,295円(税込)  (1)
(1)着心地のいい素材感と品格のあるパターンが大人見えやきちんと感じを表現してくれる「ロイヤルトラッド」シリーズのAラインスカート。幅広い着こなしが楽しめます。
- 12位
![Bonmax AS2338 [通年]ポリジン Aラインスカート[ストレッチ/千鳥格子/抗菌防臭]](https://img0.land-mark.biz/goods.img/4/42204/main.jpg)
Bonmax AS2338 [通年]ポリジン Aラインスカート[ストレッチ/千鳥格子/抗菌防臭]
商品番号: 36-AS2338 定価: 14,410円 (税込) 売価: 9,367円(税込) 銀イオンによる抗菌防臭加工のポリジン素材を使用した人気のAラインスカート。ストレッチ性抜群で動きやすい着心地です。
- 13位
![Bonmax AV1278 [通年]ポリジン ベスト [チェック/ストレッチ/抗菌防臭]](https://img0.land-mark.biz/goods.img/1/41201/main.jpg)
Bonmax AV1278 [通年]ポリジン ベスト [チェック/ストレッチ/抗菌防臭]
商品番号: 36-AV1278 定価: 18,480円 (税込) 売価: 12,012円(税込)  (2)
(2)着心地のいい素材感と品格のあるパターンが大人見えやきちんと感じを表現してくれる「ロイヤルトラッド」シリーズのベスト。幅広い着こなしが楽しめます。
- 14位

Lifemax MS1609 4.3オンス ドライロングスリーブTシャツ(ポリジン加工)(男女兼用)
商品番号: 36-MS1609 定価: 2,420円 (税込) 売価: 1,452円(税込) - 15位
![Bonmax BCP6106 [通年]ポリジン パンツ [吸汗速乾/ストレッチ/シャドーチェック]](https://img0.land-mark.biz/goods.img/1/42761/main.jpg)
Bonmax BCP6106 [通年]ポリジン パンツ [吸汗速乾/ストレッチ/シャドーチェック]
商品番号: 36-BCP6106 定価: 22,000円 (税込) 売価: 14,300円(税込)
- 16位
![Bonmax AV1281 [通年]ポリジン ベスト[ストレッチ/抗菌防臭]](https://img0.land-mark.biz/goods.img/4/41204/main.jpg)
Bonmax AV1281 [通年]ポリジン ベスト[ストレッチ/抗菌防臭]
商品番号: 36-AV1281 定価: 23,430円 (税込) 売価: 15,230円(税込) おしゃれ心を満たすやさしいツイード素材のベスト。ディテールまで計算した立体パターンで美人度をアップデート。
- 17位
![Bonmax AS2337 [通年]ポリジン プリーツスカート[ストレッチ/千鳥格子/抗菌防臭]](https://img0.land-mark.biz/goods.img/3/42203/main.jpg)
Bonmax AS2337 [通年]ポリジン プリーツスカート[ストレッチ/千鳥格子/抗菌防臭]
商品番号: 36-AS2337 定価: 14,410円 (税込) 売価: 9,367円(税込) 後ろゴム仕様でウエストがらくなプリーツスカート。裏地に抗菌防臭加工を施しニオイを防ぎます。
- 18位
![Bonmax AV1285 [通年]ポリジン ベスト[ストレッチ/千鳥格子/抗菌防臭]](https://img0.land-mark.biz/goods.img/1/42201/main.jpg)
Bonmax AV1285 [通年]ポリジン ベスト[ストレッチ/千鳥格子/抗菌防臭]
商品番号: 36-AV1285 定価: 18,480円 (税込) 売価: 12,012円(税込) 奥行きのある細やかな千鳥柄チャックのベスト。裏地に抗菌防臭加工のポリジンを採用。後ろ身頃のサイドスリット&パイピングが腰の位置を高く見せます。
- 19位
![Bonmax AS2345 [通年]ポリジン Aラインスカート[抗菌防臭/ストレッチ/ストライプ]](https://img0.land-mark.biz/goods.img/7/43117/main.jpg)
Bonmax AS2345 [通年]ポリジン Aラインスカート[抗菌防臭/ストレッチ/ストライプ]
商品番号: 36-AS2345 定価: 13,750円 (税込) 売価: 8,938円(税込) 縦長効果のある細いピッチのカラーストライプがおしゃれなAラインスカート。ストレッチが効いているのではき心地がよく、抗菌防臭で気になるニオイの発生を防いでくれるのも嬉しい。
- 20位
![Bonmax AV1277 [通年]ポリジン ベスト[無地/ストレッチ/抗菌防臭]](https://img0.land-mark.biz/goods.img/0/41200/main.jpg)
Bonmax AV1277 [通年]ポリジン ベスト[無地/ストレッチ/抗菌防臭]
商品番号: 36-AV1277 定価: 16,830円 (税込) 売価: 10,940円(税込) 着心地のいい素材感と品格のあるパターンが大人見えやきちんと感じを表現してくれる「ロイヤルトラッド」シリーズの無地ベスト。幅広い着こなしが楽しめます。
- 21位
![Bonmax BCV1109 [通年]ポリジン ベスト [背抜き仕立て/ストレッチ/吸水速乾/抗菌防臭/シャドーチェック]](https://img0.land-mark.biz/goods.img/7/42757/main.jpg)
Bonmax BCV1109 [通年]ポリジン ベスト [背抜き仕立て/ストレッチ/吸水速乾/抗菌防臭/シャドーチェック]
商品番号: 36-BCV1109 定価: 21,450円 (税込) 売価: 13,943円(税込)
- 22位
![Bonmax AV1272 [通年]ポリジン ベスト[チェック/抗菌防臭]](https://img0.land-mark.biz/goods.img/6/40216/main.jpg)
Bonmax AV1272 [通年]ポリジン ベスト[チェック/抗菌防臭]
商品番号: 36-AV1272 定価: 24,090円 (税込) 売価: 15,659円(税込) 抗菌防臭加工「ポリジン」裏地を採用したオールシーズン向けベスト。前身頃はバイアスに切替えリズム感をプラス。ウエストサイズ調整が可能な背ベルト付き。ホームクリーニングできます。
- 23位
![Bonmax BCK7105 ポリジン ラウンドネック七分袖ニット [抗菌防臭/ニット/吸水速乾/透け防止]](https://img0.land-mark.biz/goods.img/3/41223/main.jpg)
Bonmax BCK7105 ポリジン ラウンドネック七分袖ニット [抗菌防臭/ニット/吸水速乾/透け防止]
商品番号: 36-BCK7105 定価: 8,470円 (税込) 売価: 5,506円(税込) 程よい襟の開きと光沢感が上品な印象のラウンドネック七分袖ニット
- 24位
![Bonmax AS2343 [通年]ポリジン Aラインスカート[抗菌防臭][ストレッチ]](https://img0.land-mark.biz/goods.img/8/42218/main.jpg)
Bonmax AS2343 [通年]ポリジン Aラインスカート[抗菌防臭][ストレッチ]
商品番号: 36-AS2343 定価: 19,360円 (税込) 売価: 12,584円(税込) 抗菌防臭加工裏地「ポリジン」を採用したAラインスカート。ウエストを締め付けない後ろゴム仕様。
- 25位
![Bonmax AV1287 [通年]ポリジン ベスト[抗菌防臭][ストレッチ]](https://img0.land-mark.biz/goods.img/5/42215/main.jpg)
Bonmax AV1287 [通年]ポリジン ベスト[抗菌防臭][ストレッチ]
商品番号: 36-AV1287 定価: 23,650円 (税込) 売価: 15,373円(税込) 抗菌防臭裏地のポリジンを採用。落ち着いた印象のベスト。後ろ身頃のサイドベンツ&パイピングで腰位置を高く見せます。右脇にはスマホが入る深さのポケットが付いています。
- 26位
![Bonmax BCJ0711 [春夏用]ポリジン オーバーブラウス[マリンチェック/抗菌防臭/吸水速乾/]](https://img0.land-mark.biz/goods.img/1/39871/main.jpg)
Bonmax BCJ0711 [春夏用]ポリジン オーバーブラウス[マリンチェック/抗菌防臭/吸水速乾/]
商品番号: 36-BCJ0711 定価: 24,640円 (税込) 売価: 16,016円(税込)  (1)
(1)細菌の増殖を抑制するポリジン加工のオーバーブラウス。汗のニオイが気にならず、清潔感のある着こなしができます。
- 27位
![Leeメディカル LMS49001 ストレッチスクラブ[ポリジン加工]](https://img0.land-mark.biz/goods.img/5/42085/main.jpg)
Leeメディカル LMS49001 ストレッチスクラブ[ポリジン加工]
商品番号: 36-LMS49001 定価: 7,480円 (税込) 売価: 5,236円(税込)  (1)
(1)立体的な胸ポケットやガゼット、動きやすい様にゆったりとしたシルエットが特徴の半袖スクラブ。
- 28位
![Bonmax KK7126 [通年]ポリジン カーディガン[ロング丈][抗菌防臭/ニット/軽量]](https://img0.land-mark.biz/goods.img/2/43142/main.jpg)
Bonmax KK7126 [通年]ポリジン カーディガン[ロング丈][抗菌防臭/ニット/軽量]
商品番号: 36-KK7126 定価: 10,560円 (税込) 売価: 6,864円(税込) - 29位
![Bonmax AV1269 [通年]ポリジン ベスト [チェック/静電気防止/抗菌防臭]](https://img0.land-mark.biz/goods.img/2/39072/main.jpg)
Bonmax AV1269 [通年]ポリジン ベスト [チェック/静電気防止/抗菌防臭]
商品番号: 36-AV1269 定価: 21,780円 (税込) 売価: 14,157円(税込)  (2)
(2)繊細なチェック柄でOL制服として大人気な抗菌・防臭加工を施したベスト
- 30位
![Bonmax AV1273 [通年]ポリジン ベスト[ストライプ/抗菌防臭]](https://img0.land-mark.biz/goods.img/7/40217/main.jpg)
Bonmax AV1273 [通年]ポリジン ベスト[ストライプ/抗菌防臭]
商品番号: 36-AV1273 定価: 22,000円 (税込) 売価: 14,300円(税込) 4つボタンで安心感。ストライプ柄のオールシーズン向けベスト。パイピングでフレームを見せていて、バイアス方向に付けることで細く見せてくれます。ウエスト部分のパイピングが腰位置を高く見せる。
- 31位
![Rocky RC3909 [通年]長袖コンプレッション/ポリジン(男女兼用)](https://img0.land-mark.biz/goods.img/9/39949/main.jpg)
Rocky RC3909 [通年]長袖コンプレッション/ポリジン(男女兼用)
商品番号: 36-RC3909 定価: 3,520円 (税込) 売価: 1,584円(税込) - 32位
![Bonmax RB4564 [通年]ポリジン 半袖ブラウス [リボン付き/抗菌防臭]](https://img0.land-mark.biz/goods.img/5/40235/main.jpg)
Bonmax RB4564 [通年]ポリジン 半袖ブラウス [リボン付き/抗菌防臭]
商品番号: 36-RB4564 定価: 8,910円 (税込) 売価: 5,792円(税込) 襟元リボン付き(取外しOK)の半袖ブラウス。顔周りをすっきりと見せるフラットカラー。抗菌防臭加工「ポリジン」を付与。シワになりにくくアイロンの手間がかからないイージーケア性も魅力。
- 33位
![Bonmax RB4170 [通年]ポリジン 長袖ブラウス [リボン付き/抗菌防臭]](https://img0.land-mark.biz/goods.img/4/40234/main.jpg)
Bonmax RB4170 [通年]ポリジン 長袖ブラウス [リボン付き/抗菌防臭]
商品番号: 36-RB4170 定価: 9,240円 (税込) 売価: 6,006円(税込) 襟元リボン付き(取外しOK)の長袖ブラウス。上品でエレガントな印象のシャドーダイヤ素材。抗菌防臭加工「ポリジン」を付与。シワになりにいくくアイロンの手間がかからないイージーケア性も魅力。
- 34位
![Bonmax KK7125 [通年]ポリジン ニットベストカーディガン[抗菌防臭/軽量]](https://img0.land-mark.biz/goods.img/2/41222/main.jpg)
Bonmax KK7125 [通年]ポリジン ニットベストカーディガン[抗菌防臭/軽量]
商品番号: 36-KK7125 定価: 9,790円 (税込) 売価: 6,364円(税込) ケーブル編みのアクセントでエレガントな印象のニットベストカーディガン
- 35位
![Bonmax AV1290 [通年]ポリジン ベスト[抗菌防臭/ストレッチ/小柄チェック]](https://img0.land-mark.biz/goods.img/0/43120/main.jpg)
Bonmax AV1290 [通年]ポリジン ベスト[抗菌防臭/ストレッチ/小柄チェック]
商品番号: 36-AV1290 定価: 16,500円 (税込) 売価: 10,725円(税込) 優しいニュアンスのミニチェックにアクセントカラーで彩りをプラスした、トラッドなベスト。後ろはペプラムデザインでバックスタイルも美しい。
- 36位
![Bonmax AV1284 [通年]ポリジン ベスト[ストレッチ/千鳥格子/抗菌防臭]](https://img0.land-mark.biz/goods.img/0/42200/main.jpg)
Bonmax AV1284 [通年]ポリジン ベスト[ストレッチ/千鳥格子/抗菌防臭]
商品番号: 36-AV1284 定価: 16,720円 (税込) 売価: 10,868円(税込) しなやかな風合いのサプルトラッドの生地を使用。抗菌防臭加工付きでニオイを抑え衛生さをキープしてくれます。ストレッチ抜群でラクな着心地のオフィスベスト。
- 37位
![Bonmax RB4566 [通年]ポリジン 半袖ブラウス[抗菌防臭/ニット/吸水速乾/透け防止](https://img0.land-mark.biz/goods.img/0/41220/main.jpg)
Bonmax RB4566 [通年]ポリジン 半袖ブラウス[抗菌防臭/ニット/吸水速乾/透け防止
商品番号: 36-RB4566 定価: 8,690円 (税込) 売価: 5,649円(税込) 抗菌防臭加工「ポリジン」を付与したニット素材の半袖ブラウス。ニット素材だから伸縮性抜群。
- 38位
![Bonmax RB4171 [通年]ポリジン 長袖ブラウス[抗菌防臭/リボン取外し可/ニット/吸水速乾/透け防止]](https://img0.land-mark.biz/goods.img/7/41217/main.jpg)
Bonmax RB4171 [通年]ポリジン 長袖ブラウス[抗菌防臭/リボン取外し可/ニット/吸水速乾/透け防止]
商品番号: 36-RB4171 定価: 9,130円 (税込) 売価: 5,935円(税込) 抗菌防臭加工「ポリジン」を付与したニット素材の長袖ブラウス。ニット素材だから伸縮性抜群。襟元のリボンは取り外しできます。
- 39位
![Bonmax AP6256 [通年]ポリジン テーパードパンツ[抗菌防臭/ストレッチ/ストライプ]](https://img0.land-mark.biz/goods.img/8/43128/main.jpg)
Bonmax AP6256 [通年]ポリジン テーパードパンツ[抗菌防臭/ストレッチ/ストライプ]
商品番号: 36-AP6256 定価: 24,200円 (税込) 売価: 15,730円(税込)
- 40位

Lifemax MS3123 4.3オンス ドライロングスリーブポロシャツ(ポリジン加工)
商品番号: 36-MS3123 定価: 3,850円 (税込) 売価: 2,310円(税込) - 41位
![Bonmax AS2329 [通年]ポリジン タイトスカート[無地/ストレッチ/抗菌防臭]](https://img0.land-mark.biz/goods.img/7/41207/main.jpg)
Bonmax AS2329 [通年]ポリジン タイトスカート[無地/ストレッチ/抗菌防臭]
商品番号: 36-AS2329 定価: 14,300円 (税込) 売価: 9,295円(税込) 着心地のいい素材感と品格のあるパターンが大人見えやきちんと感じを表現してくれる「ロイヤルトラッド」シリーズの無地タイトスカート。幅広い着こなしが楽しめます。
- 42位
![Bonmax AS2330 [通年]ポリジン プリーツスカート[チェック/ストレッチ/抗菌防臭]](https://img0.land-mark.biz/goods.img/8/41208/main.jpg)
Bonmax AS2330 [通年]ポリジン プリーツスカート[チェック/ストレッチ/抗菌防臭]
商品番号: 36-AS2330 定価: 15,620円 (税込) 売価: 10,153円(税込)  (2)
(2)奥行きのあるチェック柄がリッチ感を高めます。着心地のいい素材感と品格のあるパターンが大人見えやきちんと感じを表現してくれる「ロイヤルトラッド」シリーズのプリーツスカート。
- 43位
![Bonmax BCS2115 [通年]ポリジン Aラインスカート [吸汗速乾/ストレッチ/シャドーチェック]](https://img0.land-mark.biz/goods.img/0/42760/main.jpg)
Bonmax BCS2115 [通年]ポリジン Aラインスカート [吸汗速乾/ストレッチ/シャドーチェック]
商品番号: 36-BCS2115 定価: 16,500円 (税込) 売価: 10,725円(税込) - 44位
![Bonmax AP6247 [通年]ポリジン 裾上げらくらくパンツ [ストライプ/抗菌防臭]](https://img0.land-mark.biz/goods.img/8/40228/main.jpg)
Bonmax AP6247 [通年]ポリジン 裾上げらくらくパンツ [ストライプ/抗菌防臭]
商品番号: 36-AP6247 定価: 26,070円 (税込) 売価: 16,946円(税込) ストライプ柄のオールシーズン向けパンツ。欄タッチでカンタンに裾上げができます。履き込みが深く、しゃがんでも背中が出にくい安心設計。静電気防止、抗菌防臭加工「ポリジン」裏地を採用しています。
- 45位

Lifemax MS1159 6.2オンス ヘビーウェイトTシャツ(ポリジン加工)(男女兼用)
商品番号: 36-MS1159 定価: 1,540円 (税込) 売価: 924円(税込)
- 46位
![Bonmax RB4565 [通年]ポリジン 半袖ブラウス[抗菌防臭/リボン取外し可/ニット/吸水速乾/透け防止]](https://img0.land-mark.biz/goods.img/9/41219/main.jpg)
Bonmax RB4565 [通年]ポリジン 半袖ブラウス[抗菌防臭/リボン取外し可/ニット/吸水速乾/透け防止]
商品番号: 36-RB4565 定価: 8,690円 (税込) 売価: 5,649円(税込) 抗菌防臭加工「ポリジン」を付与したニット素材の半袖ブラウス。ニット素材だから伸縮性抜群。襟元のリボンは取り外しできます。
- 47位
![Bonmax AS2346[通年]ポリジン Aラインスカート[抗菌防臭/ストレッチ/小柄チェック]](https://img0.land-mark.biz/goods.img/1/43121/main.jpg)
Bonmax AS2346[通年]ポリジン Aラインスカート[抗菌防臭/ストレッチ/小柄チェック]
商品番号: 36-AS2346 定価: 13,750円 (税込) 売価: 8,938円(税込)  (1)
(1)優しいニュアンスのミニチェックがトラッドな雰囲気のAラインスカート。後ろゴム仕様でラクな着心地。
- 48位
![Bonmax AS2315 [通年]ポリジン Aラインスカート [チェック/静電気防止/抗菌防臭]](https://img0.land-mark.biz/goods.img/8/39078/main.jpg)
Bonmax AS2315 [通年]ポリジン Aラインスカート [チェック/静電気防止/抗菌防臭]
商品番号: 36-AS2315 定価: 18,370円 (税込) 売価: 11,941円(税込) 後ろゴム仕様でウエスト部分がラクラク!抗菌防臭のAラインスカート
- 49位
![Bonmax AS2335 [通年]ポリジン プリーツスカート[ストレッチ/抗菌防臭]](https://img0.land-mark.biz/goods.img/3/41213/main.jpg)
Bonmax AS2335 [通年]ポリジン プリーツスカート[ストレッチ/抗菌防臭]
商品番号: 36-AS2335 定価: 19,580円 (税込) 売価: 12,727円(税込) おしゃれ心を満たすやさしいツイード素材のプリーツスカート。ディテールまで計算した立体パターンで美人度をアップデート。
- 50位
![Bonmax AV1286 [通年]ポリジン ベスト[抗菌防臭/ニット/ストライプ]](https://img0.land-mark.biz/goods.img/8/42208/main.jpg)
Bonmax AV1286 [通年]ポリジン ベスト[抗菌防臭/ニット/ストライプ]
商品番号: 36-AV1286 定価: 20,020円 (税込) 売価: 13,013円(税込) 高機能・エコ素材で伸縮性抜群のニットシリーズのベスト。オフィスから接客業まで幅広い職種に対応。しなやかな伸縮性と軽やかな着心地を兼ね備えました。





















































